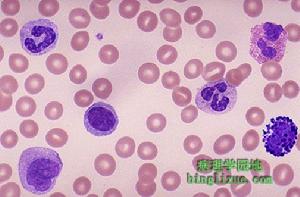
福莫司汀

簡介
藥物名稱:福莫司汀
 福莫司汀
福莫司汀英文名:Fotemustine
藥物別名:武活龍
分子式:C9H19CLN3O5P
分子式成分:(R,S)-二-乙基{1-3-(2-氯乙基)-3-亞硝基脲基 乙基}膦酸酯
類別:西醫藥物
性狀:淡黃色凍乾粉末,易溶於乙醇和水,對光敏感
藥理毒理
福莫司汀為亞硝基脲類的抗有絲分裂的細胞抑制劑,具有烷化和氨甲醯基化作用,動物實驗顯示其有廣譜抗腫瘤活性。
其化學結構中含有一個丙氨酸的生物等配物(1-氨乙基磷酸)易於穿透細胞和通過血腦屏障。
臨床評價
 骨髓抑制
骨髓抑制臨床研究表明,福莫司汀靜脈化療對於惡性膠質瘤是有效和安全的。福莫司汀以其能順利通過血腦屏障和抗腫瘤活性較高的特性,是亞硝基脲類化療的首選藥物。毒性反應有骨髓抑制和胃腸反應及輕度肝功能損害,均可在停經後自行恢復。
對34例復發性腦膠質瘤的成人患者進行研究,每人給予福莫司汀100mg·m-2,靜脈滴注,每周1次,連續3周,隨之休息5周。維持治療為每3周靜脈滴注1次。結果有24例(70%)部分有較並穩定,有效和穩定的中位反應時間為56周,生存率在12個月的為24%,18個月的為16%,3例延長生存期超過100周。臨床同樣表明,福莫司汀可使2/3復發性惡性膠質瘤患者的腫瘤延遲發展。
藥動學
人體靜脈輸注後,其血漿清除率依單次或二次冪動態變化,半衰期很短。其分子幾乎全部經代謝分解,而且血漿蛋白結合率較低(25%~30%)。
在一線化療中,本品可提高血液方面的耐受性,以往未進行化療的患者白細胞減少40.4%,曾經化療過的患者白細胞減少48.9%;以往未進行化療的患者血小板減少33.9%,曾經化療過的患者血小板減少40.4%(n=153)。
體內過程
人靜脈注射14C標記的本品,血漿原藥濃度迅速下降,半衰期為23.2分鐘,分布容積為32L。 肝臟
肝臟血漿清除率與肝臟血流量有關,為1100ml/min;主要從尿中排出,7日後尿排泄>50%,糞中排出<10%,呼吸中以CO2形式排出<0.1%。
本品有較好的細胞膜穿透性及組織分布,能透過血腦屏障,在亞硝脲類藥物中,其穿透力最強。
適 應 證
(1)惡性黑色素瘤和晚期癌症。
(2)不宜手術的原發性腦腫瘤。
(3)多發性淋巴轉移性惡性腫瘤和白血病。
不良反應
 血細胞
血細胞若在本品治療之前進行過其他化療或與其他可能誘發血液毒性的藥物聯合套用時,可加重血液學毒性。
此外還有用藥後2h內出現中度噁心和嘔吐(46.7%)、中度暫時性可逆性轉氨酶、鹼性磷酸酶及膽紅素升高(29.5%)、發熱(3.3%)、注射部位靜脈炎(2.9%)、腹瀉(2.6%)、腹痛(1.3%)、暫時性血尿素氮升高(0.8%)、瘙癢(0.7%)、暫時性可逆性神經功能障礙(意識障礙、感覺異常、味覺缺失)(0.7%)。
相互作用
本品與大劑量的達卡巴嗪(400~800mg·m-2)合用出現肺部毒性表現(成人呼吸窘迫綜合徵),當聯合套用時,推薦按照下列交替用藥方案:本品d1和d8各用100mg·m-2;達卡巴嗪d15,d16,d17,d18連續用,劑量為250mg·m-2·d-1。
用法用量
 白細胞
白細胞靜脈注射給藥,每次劑量100mg/平方米,1次/周,連續給藥3周,之後進行常規維持治療,每3周給藥1次。注射劑,4ml/支,含藥200mg;2ml/支,含藥100mg。
(1)治療過程中應密切檢查血常規,特別注意血小板和中性粒細胞數的改變,並及時調整劑量,血小板低於9萬/立方毫米,白細胞低於3000/立方毫米要特別注意,或停藥待其適當恢復。(2)留意肝、腎功能改變。(3)胃腸道症狀可適當對症處理。
注意事項
粒細胞
粒細胞①不推薦將本品用於過去4周內用過化療或6周內用過亞硝基脲類藥物治療的患者。
②本品只可考慮用於血小板和/或粒細胞計數分別≥1×1012·L-1和≥2×109·L-1的患者。每次用藥前,都應做血細胞計數,並根據血液學狀態調整劑量。
③從誘導治療開始到維持治療開始,推薦的間隔是8周,在2個維持治療周期之間,推薦的間隔期是3周。推薦在誘導治療中或後進行肝功能檢查。
相互作用
與所有細胞毒藥物有相同的相互作用
1.因為腫瘤增加了血栓的危險,通常採用抗凝血治療。腫瘤病例中血液凝固性存在很大的個體間差異,從而增加了口服抗凝血劑與抗腫瘤化療之間相互作用的不測事件。因此,如若決定患者口服抗凝血劑治療,需要增加INR檢驗的次數。
 黃熱病
黃熱病1)苯妥英(為了預防某些抗腫瘤藥物誘發的驚闕時套用)
套用阿黴素、柔紅黴素、卡鉑、順鉑、卡莫司汀、長春新鹼、長春鹼、博來黴素、甲氨蝶呤時,由於細胞增殖抑制劑導致苯妥英在消化道吸收的減少,從而誘發驚闕的發作。可短時間與抗驚厥的苯二氮卓類藥合用。
2)黃熱病疫苗引致廣泛致命的疫苗疾病的危險。
3.聯合用藥需考慮
1)環孢菌素(阿黴素、依託泊甙);可能有過度的免疫抑制,導致淋巴組織增生的危險性。
2)免疫抑制劑(由環孢菌素外推法得出);過度的免疫抑制,導致淋巴細胞增生的危險性。
4.本品與達卡巴嗪特定的相互作用:
當本品與大劑量的達卡巴嗪在同一天同時套用時偶爾會發生肺毒性(急性成年人呼吸窘迫綜合症),注意避免此種給藥方法。
應根據下述推薦方法進行聯合用藥:
1)誘導治療:
福莫司汀100mg/m2/天,在第1天和第8天。
達卡巴嗪250mg/m2/天,在第15,16,17和18天。
5周的治療休息期。
2)維持治療褔莫司汀100mg/m2/天,第1天。
達卡巴嗪250mg/m2/天,在第2,3,4,5天。
製劑規格
注射用凍乾粉劑:208.0mg/瓶;200mg/4mL。
避光,2~8℃貯存。
禁忌
對本品過敏,造血功能不良和孕婦禁用。
